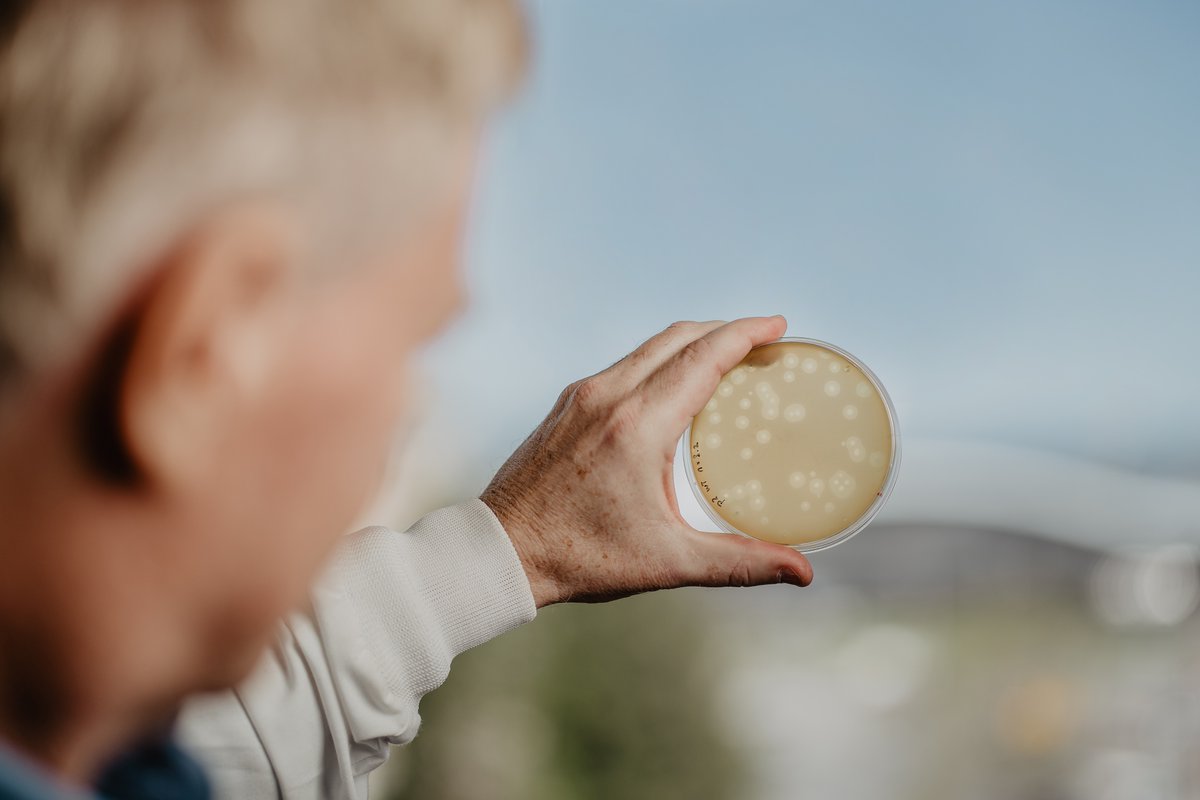
Some dairy #phages make nice plaques ...
But, we still want to get rid of them 😉

Sylvain Moineau
@smoineau
Professeur, département de biochimie, microbiologie et bio-informatique, Université Laval, Québec, Canada
moineau.bcm.ulaval.ca
ID: 466082595
17-01-2012 01:42:14
426 Tweet
1,1K Followers
275 Following









Excited to share this superbe work by Frank Oechslin, in collaboration with Xiaojun Zhu, Carlee Morency, Vincent (Vincent Somerville), and Rong Shi. IBIS-ULAVAL PROTEO Fermentation practices select for thermostable endolysins in phages 👇 academic.oup.com/mbe/advance-ar…


Congrats to Alessandra Melo and Carlee Morency 👇 Virulence-associated factors as targets for phage infection sciencedirect.com/science/articl… And many thanks to Rob Lavigne and FrunzkeLab for this opportunity #phage #bacteriophage





Great collaboration with Simon Barnabé group at UQTR and their industrial partner Kruger inc. #phages in coated-papers for food packaging sciencedirect.com/science/articl…